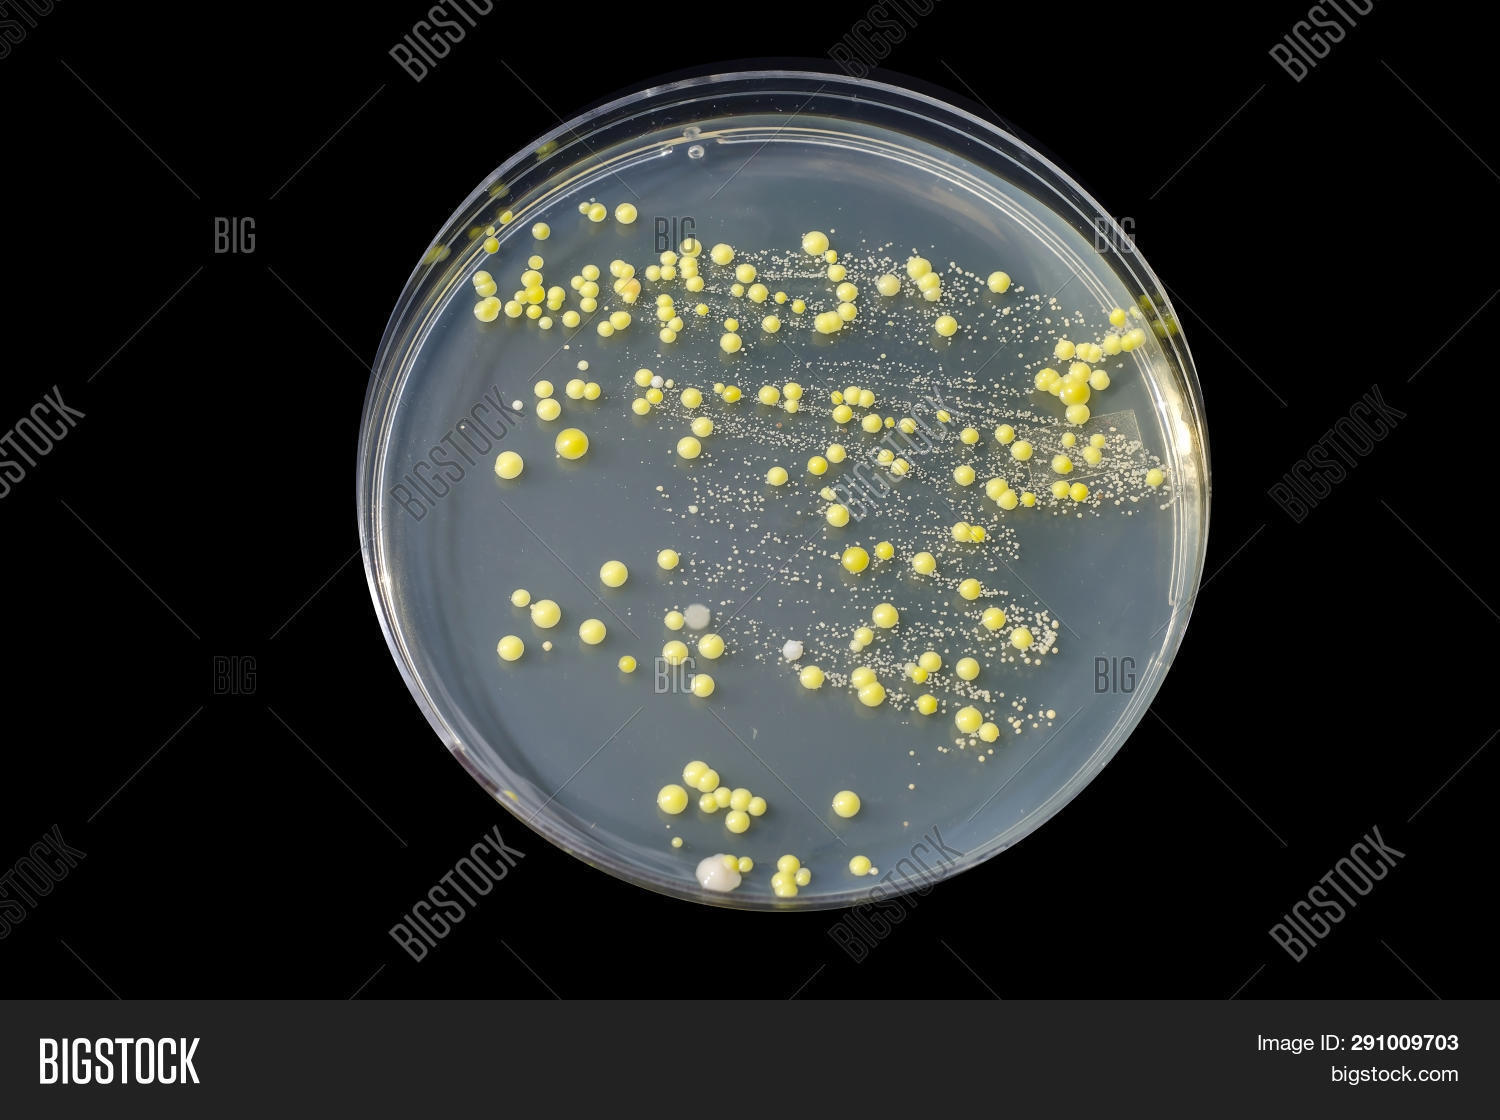
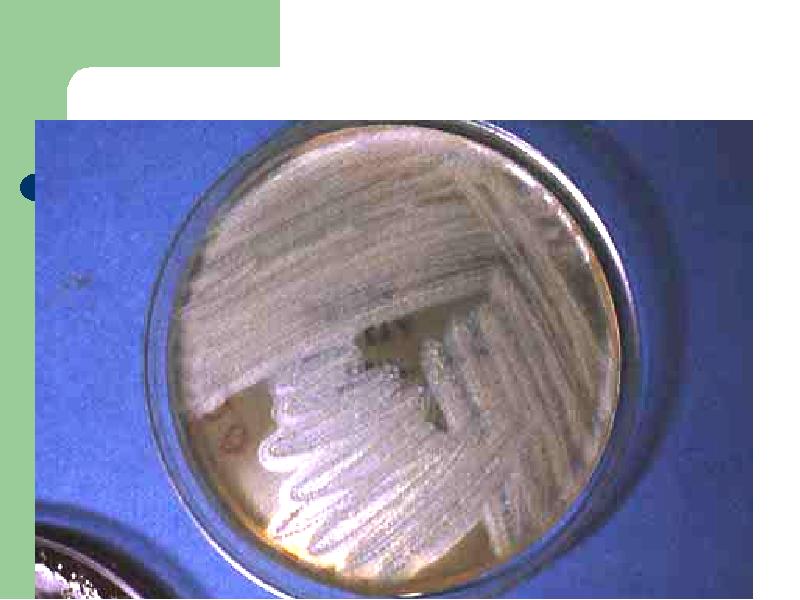

Лецитиназа это
Песня полем полем белым снегом
Циновка на пол в прихожую на озон
Чайник polly
Ремстрой кондиционеры
Рама бич кемер
Вахта лесовоз
Who is person in your country
University of the nations
Как понять кого добавили в друзья
В кс 2 есть боты
Mc jackson
Устал но не могу уснуть
Задачи на поисковые запросы информатика
Лецитиназа это 118 фото